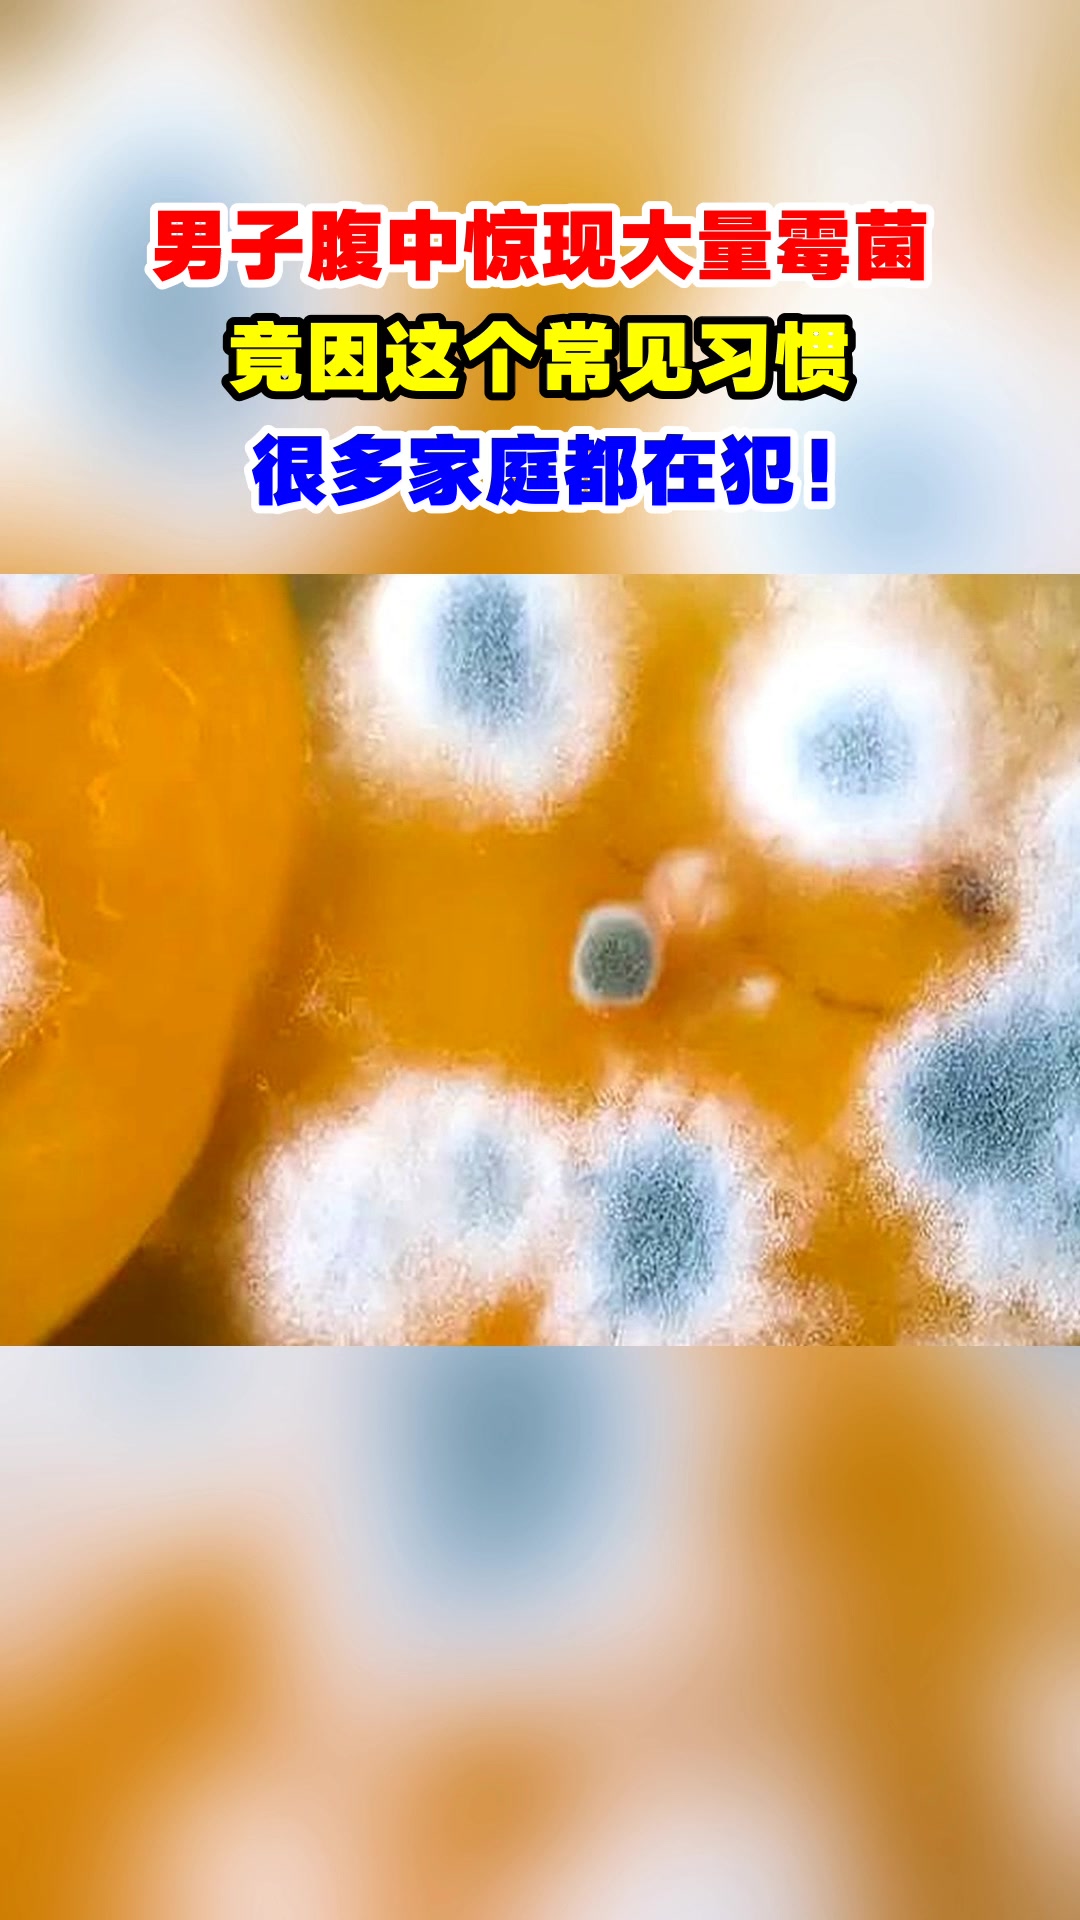
男子腹中惊现大量霉菌,竟因这个常见习惯,很多家庭都在犯!

橙色的霉菌

橘色还是粉色的,细菌,哇哦#细菌#家里养出细菌#橘色的霉菌
图片尺寸1440x1920
岩石上的橙色霉菌
图片尺寸1200x669
霉菌在发霉的水稻上迅速生长
图片尺寸1200x803
黄曲霉菌
图片尺寸900x1200
霉菌在发霉的水稻上迅速生长
图片尺寸1200x801
美丽的橙色地衣真菌霉菌在白石海边
图片尺寸700x466
橙色的,上面有霉菌.腐烂的橙色
图片尺寸800x1200
曲霉菌菌落总数检测 霉菌检测机构 菌种鉴定介绍
图片尺寸640x480
树上的橙色真菌
图片尺寸1200x801
白色背景上的霉菌橙色照片摄影图片
图片尺寸1600x1067
男子腹中惊现大量霉菌,竟因这个常见习惯,很多家庭都在犯!
图片尺寸1080x1920
白色背景上的霉菌橙色照片摄影图片
图片尺寸612x408
橙色的,上面有霉菌.腐烂的橙色
图片尺寸1200x800
橘子发霉 一堆好好的,就它自己发了霉
图片尺寸1440x1920
白色背景上的霉菌橙色照片摄影图片
图片尺寸612x408
发霉的食物
图片尺寸1080x1440
白色背景上的霉菌橙色照片摄影图片
图片尺寸612x408
霉菌落生长在老水稻表面
图片尺寸1200x1040
我竟然忘记了高压锅里的米饭,放的时间太久了,全
图片尺寸366x366
这是什么菌,让橙色橘子变成这样的颜色,表面还飞灰呢!
图片尺寸1920x1080